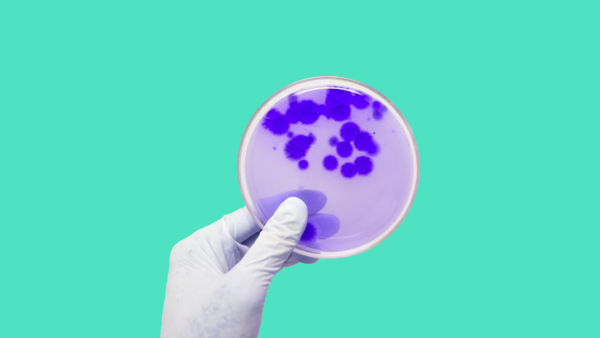
A petri dish represents antibiotics that cause C.Diff

Michael L. Davis, MD
Medical Reviewer Member of the SingleCare Medical Board
Michael L. Davis, MD, is a family medicine specialist in Florida.
Sign up for health updates in your inbox
Articles

Health Education
Is pneumonia contagious? Who is at risk and how to prevent it
Bacterial and viral forms of pneumonia are contagious. Learn how pneumonia spreads.
Updated on May 4, 2022

Health Education
Common causes of foot pain and how to treat them
Experiencing any type of foot pain can make daily life uncomfortable. Feet…
May 7, 2020

Wellness
What are carbs? Everything you need to know about carbohydrates
Picture this... You're driving around, looking for a dinner spot, and Olive…
Apr. 29, 2020

Health Education
A guide to sleep aids: What are your options?
It’s 3 a.m. and you’ve been tossing and turning for hours. It’s…
Feb. 28, 2020

Drug Info
ACE inhibitors vs. beta blockers: Which blood pressure medicatio...
Seventy-five million American adults have high blood pressure (hypertension), but only 54%…
Feb. 19, 2020

Community
What it’s like living with hypothyroidism
When I was 18 years old, I was diagnosed with hypothyroidism—essentially my…
Jan. 1, 2020
Health Education
8 antibiotics that cause C.Diff
The introduction of antibiotics to cure infections undoubtedly revolutionized medicine over the…
Oct. 16, 2019

Drug Info
Is it safe to combine medication for ADHD and alcohol?
When you think of ADHD, you probably think of hyperactive kids. But…
Oct. 11, 2019

Health Education
How to find an erectile dysfunction doctor and what to expect
If you’re experiencing erectile dysfunction (ED), you may be wondering which doctor…
Oct. 2, 2019

Health Education
6 ADHD myths and misconceptions
Attention deficit hyperactivity disorder (ADHD or ADD) affects over 8% of children…
Updated on Mar. 29, 2023

Health Education
Guide to erectile dysfunction pills, drugs, & medications
By age 70, nearly 70% of men in the United States will…
Sep. 2, 2019


